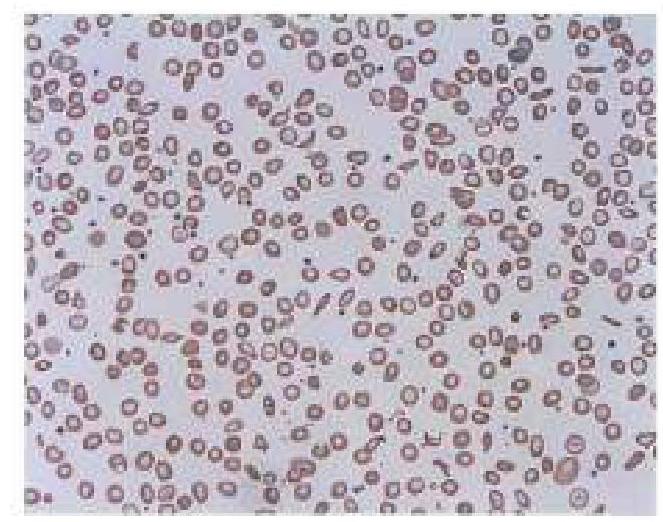
Image for question 10

Which disease is most closely associated with intensive international surveillance for global eradication?
Which of the following causes Melioidosis?
A young man, home on leave from the military, went camping in the woods to detect deer movement for future hunting. Ten days later, he developed fever, malaise, and myalgia. Leukopenia and thrombocytopenia were observed, as well as several tick bites. Which of the following statements best describes human monocytic ehrlichiosis (HME)?
A diabetic patient developed cellulitis due to S. aureus, which was found to be methicillin resistant on the antibiotic sensitivity testing. All of the following antibiotics will be appropriate except ?
Lyme disease is caused by:
Insane paresis is associated with -
All the following statements are true regarding beta-lactams except:
Botryomycosis is a ___ disease
An adult man presents with the clinical condition shown in the image, and a Gram stain reveals Gram-negative diplococci. What is the most appropriate treatment?

All of the following statements are true regarding neutrophil extracellular trapping (NET) except for which of the following?
Get full access to all questions, explanations, and performance tracking.
Scan to download app